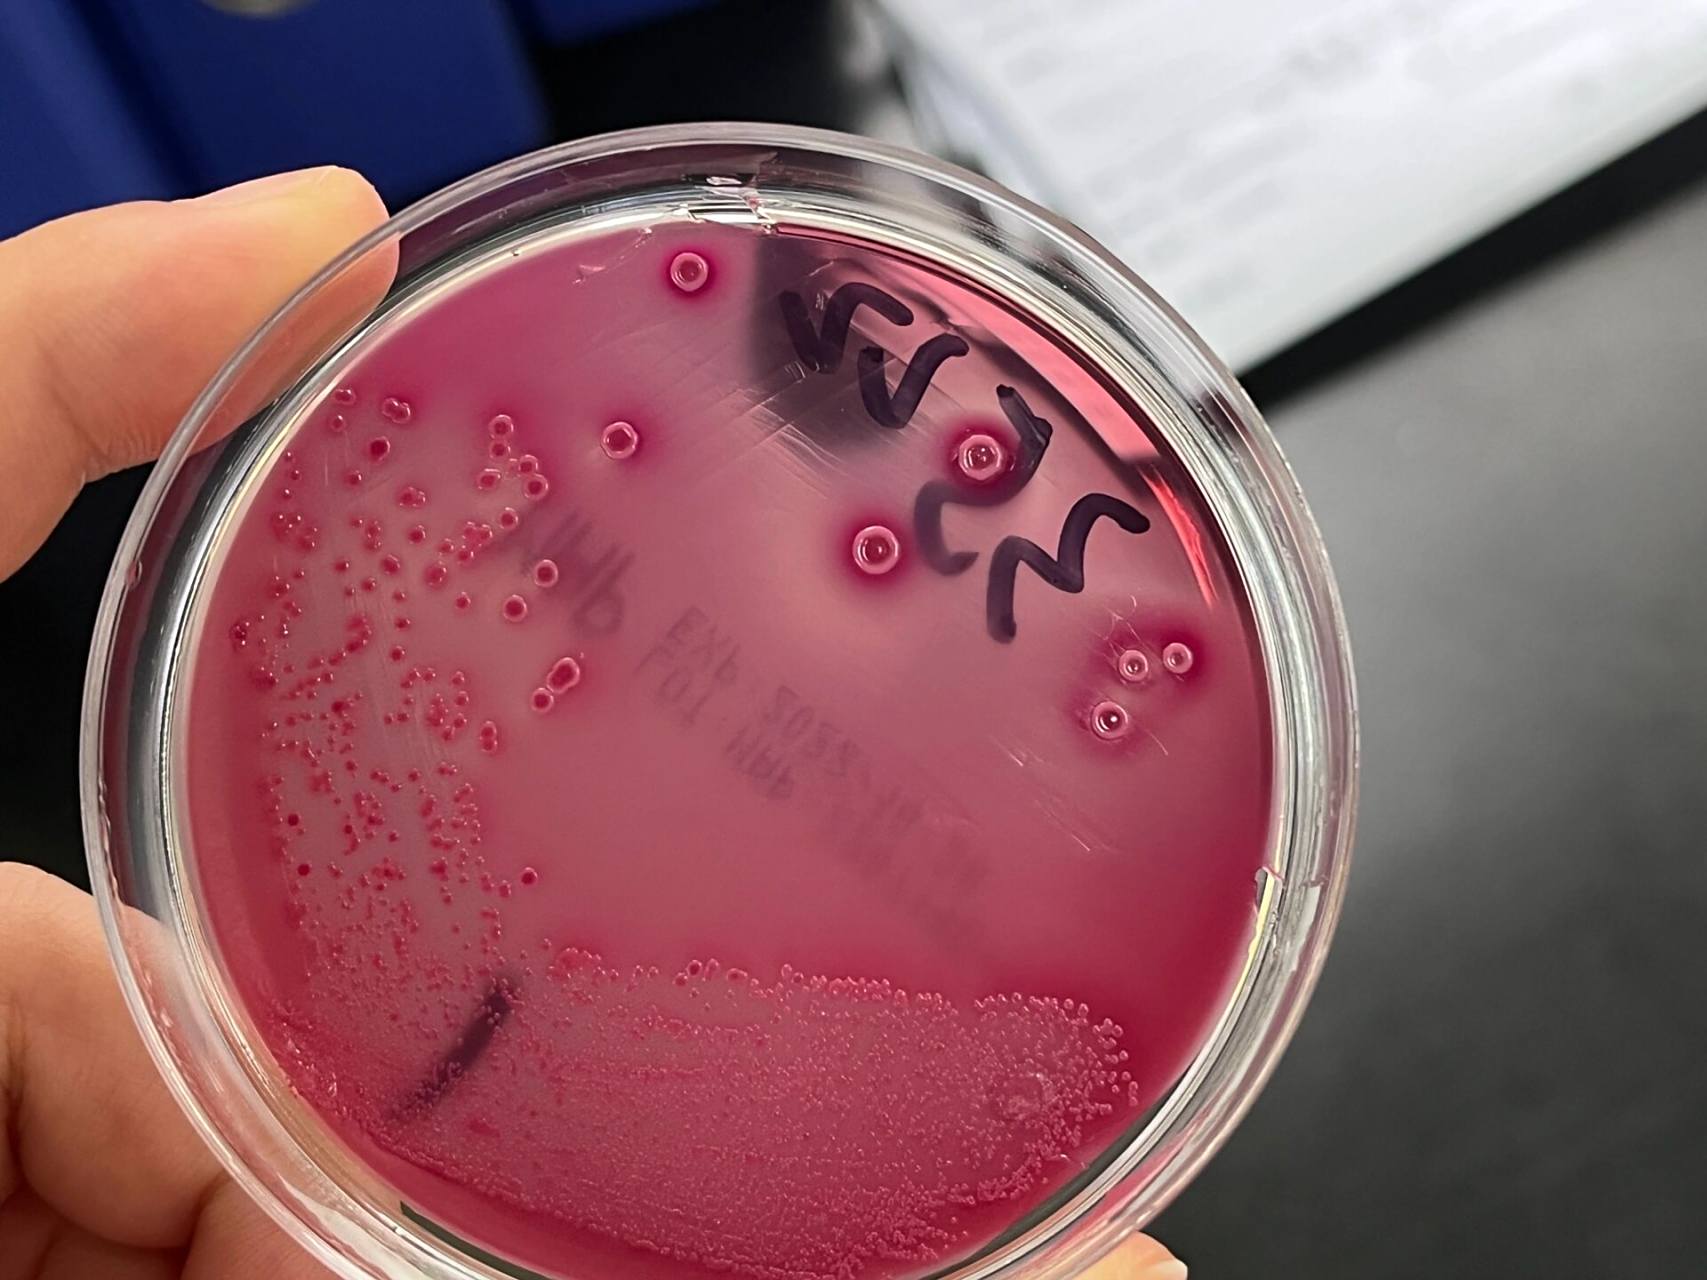
第一次见不分解乳糖的大肠埃希菌 p1 麦康凯平板无色,不分解乳糖为不

大肠埃希菌

放大版的大肠埃希菌
图片尺寸1080x1440
分享大肠埃希菌两种不同的形态~真的千差万别
图片尺寸962x1280
大肠埃希菌
图片尺寸300x284
大肠埃希氏杆菌
图片尺寸300x300
大肠埃希菌丽都是良的
图片尺寸1440x2116
咽拭子中培养的大肠埃希菌究竟有何意义?
图片尺寸278x291
美利用大肠埃希菌制成细菌计算机
图片尺寸500x400
大肠埃希氏菌
图片尺寸596x495
致泻性大肠埃希氏菌
图片尺寸370x328
宠物消毒:大肠埃希菌病,预防在前,消毒在后
图片尺寸660x336
大肠埃希氏菌
图片尺寸400x227
第一次见不分解乳糖的大肠埃希菌 p1 麦康凯平板无色,不分解乳糖为不
图片尺寸1707x1280
都是大肠埃希菌你知道为什么差异会如此大?
图片尺寸1080x1439
haccp,食品安全,质量控制,品质控制,标准 电子显微镜下 的大肠埃希氏
图片尺寸1080x810
肠出血性大肠埃希杆菌
图片尺寸500x583
大肠埃希氏菌计数方法
图片尺寸1000x334
微生物大肠埃希菌
图片尺寸1080x1439
大肠埃希菌
图片尺寸750x472
大肠埃希氏大肠杆菌照片
图片尺寸450x300
一例l型细菌大肠埃希菌感染病例分析
图片尺寸660x567